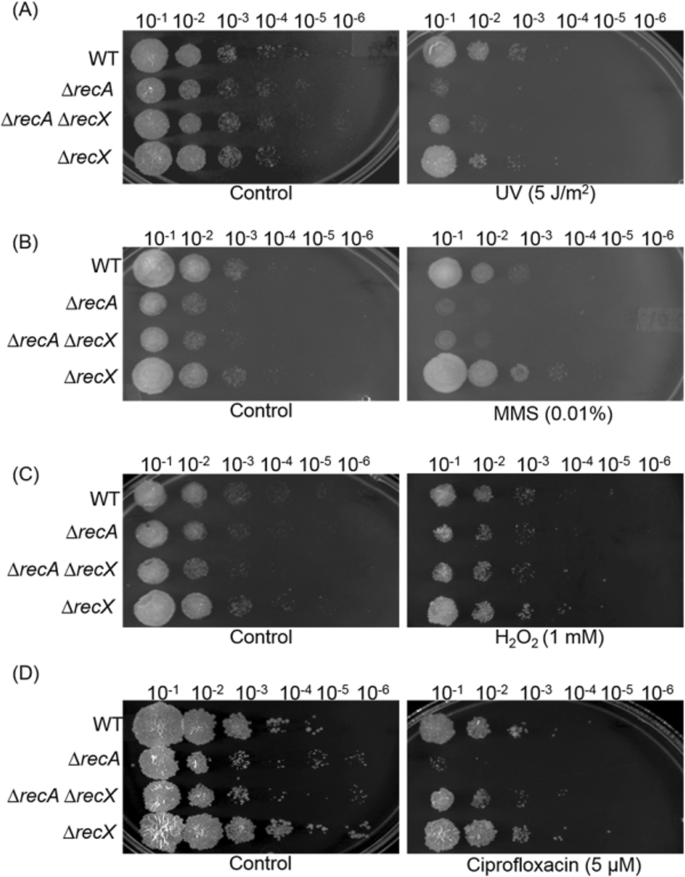
figure 6

Abstract
The RecX protein has attracted considerable interest because the recX mutants exhibit multiple phenotypes associated with RecA functions. To further our understanding of the functional relationship between recA and recX, the effect of different stress treatments on their expression profiles, cell yield and viability were investigated. A significant correlation was found between the expression of Mycobacterium smegmatis recA and recX genes at different stages of growth, and in response to different stress treatments albeit recX exhibiting lower transcript and protein abundance at the mid-log and stationary phases of the bacterial growth cycle. To ascertain their roles in vivo, a targeted deletion of the recX and recArecX was performed in M. smegmatis. The growth kinetics of these mutant strains and their sensitivity patterns to different stress treatments were assessed relative to the wild-type strain. The deletion of recA affected normal cell growth and survival, while recX deletion showed no significant effect. Interestingly, deletion of both recX and recA genes results in a phenotype that is intermediate between the phenotypes of the ΔrecA mutant and the wild-type strain. Collectively, these results reveal a previously unrecognized role for M. smegmatis recX and support the notion that it may regulate a subset of the yet unknown genes involved in normal cell growth and DNA-damage repair.
Similar content being viewed by others
Introduction
To maintain genomic integrity, bacteria have developed a complex network of DNA-damage response (DDR) pathways to sense, respond to, and repair different types of DNA damage1,2,3. In Escherichia coli, DNA damaging agents induce the SOS regulon - an adaptive stress response - that contributes to cell survival. Most notably, SOS induction increases the mRNA and protein levels of approximately fifty genes belonging to the SOS regulon through RecA-dependent autocatalytic cleavage of the LexA repressor1,4,5. Multiple investigations have established that mutations in E. coli recA are pleiotropic, affecting not only homologous recombination (HR) but also DNA repair, DNA replication, mutagenesis and cell division through the SOS response1,4,6,7. These crucial functions are carried out by a helical RecA nucleoprotein filament through three distinct, but related biological processes: (a) recombination-based DNA repair; (b) transcriptional upregulation of SOS genes through cleavage of the LexA repressor and (c) error-prone replication by DNA polymerase IV4,5.
In E. coli, a variety of accessory proteins regulate RecA function and amongst these the single-stranded binding (SSB) protein and RecFOR abet RecA in the formation of nucleoprotein filaments on single stranded DNA (ssDNA)4,7,8. Two different types of accessory factors, referred to as RecA mediators and RecA modulators, act at different levels to regulate the formation and/or stability of the RecA-ssDNA filament8,9,10. The RecA mediators act during the binding of RecA on SSB-coated ssDNA. In contrast, the RecA modulators regulate the function of the nucleoprotein filament during the search for homology and/or strand exchange. The well characterized RecA mediators, SSB, RecF, RecO and RecR, act in overcoming the barrier to RecA filament nucleation and stimulate the rate of its polymerization4,7,8,11. Differing from these mediators, DinI and RecX proteins modulate RecA protein function but have very different effects12,13. Whilst DinI stabilizes RecA nucleoprotein filaments, RecX binds to RecA in solution and also inhibits RecA nucleoprotein elongation and its biochemical functions14,15. Other known negative modulators include RdgC and PsiB: whereas RdgC acts as a negative regulator of RecA protein functions, PsiB binds to the RecA that is free in solution and the resultant complex impedes the formation of RecA nucleoprotein filaments16,17,18,19. Another accessory factor, RecN, a bacterial SMC (Structural Maintenance of Chromosome)-like accessory protein, stimulates the DNA strand-invasion step of RecA-mediated recombination-based DNA repair20. However, the functional and mechanistic properties of RecA accessory factors in mycobacteria are not well understood.
The RecX protein has attracted much interest because the recX mutants exhibit multiple phenotypes associated with RecA functions. The Mycobacterium tuberculosis RecX was first identified for its ability to suppress DNA pairing and strand exchange, ATPase and co-protease activities of RecA14. Unsurprisingly, the E. coli and Deinococcus radiodurans RecX proteins were also shown to modulate the biochemical activities of their cognate RecA proteins in a similar fashion13,15,21. However, the mechanisms by which RecX affect the biochemical activities of RecA remain controversial and are still being defined. For instance, E. coli RecX, which is far less abundant in the cell, interacts with DNA but it is not clear how such an interaction relates to its capacity to inhibit RecA activities. Furthermore, the mechanism by which RecF antagonizes the E. coli RecX promoted destabilization of RecA nucleoprotein filaments is not well understood22. The electron microscopy reconstructions of mixed RecA-RecX filaments revealed that RecX binds within the helical groove of the RecA nucleoprotein filament23. As a result, a repression of HR might ensue by the steric clash of RecX with the process of DNA strand exchange and impede the ATP-coupled allosteric changes in RecA14,23,24. Studies in Bacillus subtilis suggest that RecX facilitates HR by modulating RecA activities by inhibiting RecA25 and RecX aids all RecA-related processes in Neisseria gonorrhoeae26. Other studies have found that mechanical forces antagonize the inhibitory effects of M. tuberculosis RecX, and a partially de-polymerized RecA filament could re-polymerize in the presence of RecX27. Although these findings shed light on the role of RecX, the molecular mechanisms that underlie the variety, magnitude and taxa specific activities are not fully understood.
Moreover, very little is known about the in vivo functional relationship between recA and recX, especially in intracellular bacterial pathogens. M. tuberculosis is the causative agent of tuberculosis, which is characterized by slow growth. Therefore, M. smegmatis is often used as a surrogate model to study the pathogenesis of mycobacterial infection and drug resistance. Further, investigations into the interaction mechanisms between M. smegmatis recX and recA might reveal insights into the phylogenetic diversification among the mycobacterial species. To this end, M. smegmatis ΔrecX and ΔrecAΔrecX mutants were constructed and subjected to various stress conditions. The growth phenotypes of these mutants and recA and recX gene expression profiles were compared with those of the wild-type strain. In the absence of DNA damage, recX was found to be non-essential for M. smegmatis growth, and ΔrecAΔrecX double mutant strain exhibits a phenotype that is intermediate between the phenotypes of the ΔrecA mutant and the wild-type strain. Additionally, a significant correlation was seen between the expression of the recA and recX at different stages of growth and after exposure to DNA damaging agents, albeit recX exhibiting lower transcript and protein abundance at the mid-log and stationary phases of growth. Collectively, these results suggest a previously unrecognized role for M. smegmatis recX and support the idea that it may regulate a subset of the yet unknown genes involved in normal cell growth and DNA damage repair.
Methods
Chemicals and enzymes
All the chemicals were purchased from Sigma-Aldrich (St. Louis, MO). All restriction endonucleases, Phusion polymerase, Klenow polymerase and T4 DNA ligase were purchased from New England Biolabs (Ipswich, MA). Pure H2O2, methylmethane sulphonate (MMS), ciprofloxacin, kanamycin and hygromycin were purchased from Sigma-Aldrich (St. Louis, MO). RT-qPCR reagents, SYBR RT-qPCR master mix and cDNA synthesis kit were obtained from Bio-Rad Laboratories (Hercules, CA). The DNA oligonucleotides were synthesized by Sigma-Genosys (Bangalore, India) and [α-32P]ATP was purchased from the Board of Radiation and Isotope Technology (Hyderabad, India).
Bacterial strains, plasmids and growth conditions
Bacterial strains and plasmids used in this study are described in Table 1. The M. smegmatis mc2155 ΔrecX and ΔrecAΔrecX strains were generated as described28. The pJV53 vector (encoding mycophage derived recombinases under acetamide-inducible promoter was transformed into M. smegmatis mc215528. The ΔrecAΔrecX and ΔrecX mutants were derived from M. smegmatis mc2155 strain. These strains were grown in liquid 7H9 Middlebrook broth (Difco Laboratories, Detroit, MI) supplemented with 0.05% Tween 80 and 10% albumin-dextrose-catalase (ADC) (henceforth referred to as 7H9 broth) with continuous agitation (120 rpm) at 37 °C for 2 days. M. smegmatis mc2155 was grown on 7H10 agar (4.7 g/L) plates supplemented with 10% ADC. The starter cultures were prepared by inoculating a single colony of M. smegmatis mc2155 into 15 ml of 7H9 broth and grown at 37 °C in a shaking incubator (120 rpm), until the cultures reached an OD600 of 1. Then 1.5 ml of the cell suspension was inoculated into 30 ml of 7H9 Middlebrook medium to give an OD600 of 0.05. The antibiotics (kanamycin and hygromycin) were added to a final concentration of 25 µg/ml and 100 µg/ml respectively.
The M. smegmatis ΔrecA mutant was a kind gift from Elaine O. Davis, National Institute for Medical Research, London. The characteristics of plasmids (pJV53, pVV16 and p0004S) have been described elsewhere29. The bacterial cultures were exposed to a UV lamp (UVP Inc. San Gabriel, CA) at 254 nm for different time intervals ranging from 5 to 20 sec. The dosage was measured using a radiometer (UVItec Ltd, Cambridge, UK).The E. coli DH5α strain (Novagen, Madison, WI) was used in the recombinant DNA experiments. The cultures were incubated at 37 °C with shaking at 120 rpm, and OD600 values were recorded every 3 h, until the cultures reached an OD600 of 2.5.
Cloning of recA and recX genes
M. smegmatis recA (MSMEG_2723) and recX (MSMEG_2724) ORFs were obtained from the SmegmaList website (http://svitsrv8.epfl.ch/mycobrowser/smegmalist.html). The coding sequences of recA and recX were amplified by PCR using gene-specific forward and reverse primers (Table 2). The pVV16-vector was digested with NdeI and HindIII. The PCR products were gel purified, and ligated separately into the linear plasmid pVV16 DNA at
NdeI/HindIII site. The resulting plasmids contained either full-length M. smegmatis recA or recX genes under the control of the Hsp60 constitutive promoter.
Complementation assay
The complementation assay was performed using M. smegmatis mc2155 ΔrecA, ΔrecAΔrecX and ΔrecX mutant strains. The plasmid complemented strains bearing wild-type copies of M. smegmatis recA or recX ORFs were created by electroporation. These were grown in liquid 7H9 broth to mid-log phase, until cultures reached an OD600 of 0.6. The cultures were centrifuged and pellets were resuspended to an OD600 of 0.8 in sterile Milli-Q water. An aliquot from each culture was serially diluted and spotted on 7H10 agar plate containing 100 µg/ml of hygromycin B. The cells were exposed to 10 J/m2 of 254 nm UV light and incubated at 37 °C in the dark for 3 days. The images were acquired in the digitization mode using a Quant LAS 4000 imaging system (GE Healthcare, Piscataway, NJ).
Construction of recX and recA-recX gene replacement mutants in M. smegmatis
The DNA manipulations were carried out using standard protocols30. Plasmid DNA and DNA fragments were isolated from the gels using Qiagen miniprep kit (Qiagen India, New Delhi) according to the manufacturer’s instructions. The genomic DNA of M. smegmatis was PCR-amplified as described31. The electrocompetent M. smegmatis mc2155 cells were prepared and stored as described32. The construction of allelic exchange substrate (AES) and its subsequent delivery to the recombineering strain of M. smegmatis mc2155 was carried out as described28. Table 3 shows the sequences of upstream and downstream primers corresponding to the M. smegmatis recA-recX locus. For recX gene deletion, the upstream and downstream flanking regions of M. smegmatis mc2155 recX were PCR-amplified from the genomic DNA using specific primers that contained the restriction sites in the counter-selectable vector p0004S. The upstream and downstream flank fragments were digested with PflMI and directionally cloned on either side of the Hyg resistance gene to generate the recX-AES. To generate allelic exchange substrates, the upstream and downstream flanking sequences of recA-recX locus were PCR-amplified using genomic DNA as the template and specific primers. The amplified products were digested with PflMI and directionally cloned on either side of the Hyg resistance gene. The resulting constructs were independently transformed into E. coli DH5α and plated on LB agar containing 100 μg/ml of hygromycin. The positive clones were identified by restriction analysis of the isolated plasmid using EcoRV to generate the linear blunt-ended recombineering-proficient (containing upstream region-hygr-downstream region) DNA fragments.
Preparation of M. smegmatis mc2155 recombineering strain and construction of ΔrecX and ΔrecAΔrecX strains
The M. smegmatis mc2155 derivative harbouring the pJV53 vector was used in recombineering28. The AES constructs generated for disruption of recX and recArecX were linearised using EcoRV and then isolated by electroelution. The linearized AES constructs (100 ng each), were independently electroporated into the M. smegmatis mc2155 recombineering strain. The transformed cells were cultured with shaking at 37 °C for 4 h. The transformants were plated on 7H10 agar plates, supplemented with 100 μg/ml hygromycin B and 25 µg/ml kanamycin. The transformants were selected and their genomic DNA was isolated and analyzed by PCR to ascertain recombination in the M. smegmatis mc2155 genome at the allelic site.
Southern blot hybridization
The genomic DNA from the M. smegmatis mc2155 wild-type, ΔrecA and ΔrecAΔrecX strains was isolated to confirm deletion of the recX and recArecX genes31. The probe (548 bp) corresponding to the upstream region of recA was PCR-amplified using forward (5′ GCTCACCTCCATCGACAGGATCCT 3′) and reverse primers (5′ GGTGCCTCTCCGAGTAGTCGTGTC 3′). The PCR amplified product (labelled probe) was prepared using [α-32P]ATP, random primers (hexamer) and Klenow polymerase as described (30). The radiolabeled probe was heat denatured at 95 °C for 10 min followed by snap-chill prior to use. Approximately 10 µg of genomic DNA was digested using NdeI and SalI (10 U each) at 37 °C overnight and the DNA fragments were separated by 0.8% agarose gel electrophoresis. The gel was soaked in 0.25 N HCl for 20 min followed by washing twice with 40 ml of sterile water. Subsequently, the gel was submerged in a solution containing 0.5 N NaOH and 0.6 M NaCl for 15 min each to denature the DNA, followed by neutralization of the gel pH in a buffer containing 1.5 M NaCl and 0.5 M Tris-HCl (pH 7.5) for 30 min, and finally in 10X SSC (pH 7). The DNA was transferred by capillary action to a nylon membrane and was fixed to dry membranes by exposure to UV light at 254 nm using a Stratalinker (Stratagene Corporation, La Jolla, CA). The nylon membrane was soaked in a pre-hybridization buffer (0.5 M phosphate buffer pH 7, 7% SDS, 1 mM EDTA) by gentle shaking for 1 h at 65 °C and then hybridized using the 32P-labelled probe at 65 °C for 16 h. Following hybridization, the membrane was washed with 1X SSC and 0.1% SDS to remove the unbound probe. The bands were visualised using the Fuji FLA 9000 phosphorimager.
Analysis of M. smegmatis recA and recX gene expression under hypoxic conditions
Wayne and Hayes dormancy culture system was used to study the hypoxic response of M. smegmatis recA and recX expression as described33,34. Briefly, M. smegmatis mc2155 strain was grown as described above until the culture reached an OD600 of 0.6. An aliquot of the culture was diluted in Middlebrook 7H9 broth to an OD600 of 0.05. Equal volumes (5 ml) of diluted culture were placed in each of 100 ml screw-cap flasks having a headspace ratio of ~ 0.5 (35 ml of head space air vol. to 65 ml of liquid medium) containing a stir bar. The cultures were gently shaken (120 rpm) at 37 °C. To ascertain hypoxic culture conditions, we used a standard color assay (viz., methylene blue reduction)35. Methylene blue (1.5 μg/ml) was added to cultures, and reduction was monitored visually (by decolorization). To avoid aeration of cultures during sampling, separate flasks were used for each time point in these experiments. A small portion of the culture from each flask was used for Western blot analysis, while the rest was used for total RNA extraction and RT-qPCR as described below.
DNA damage-sensitivity assays
The M. smegmatis mc2155 wild-type, ΔrecA, ΔrecX and ΔrecAΔrecX strains were grown in 7H9 broth to mid-log phase to a cell density of 0.6. After 3 h of incubation with different concentrations of ciprofloxacin, MMS or hydrogen peroxide, the cells were collected by centrifugation and resuspended in 1 ml sterile Milli-Q water at a cell density of 0.8. A portion of the resuspended cells were serially diluted and spotted on 7H10 agar plates containing 100 µg/ml hygromycin B. Similarly, the serial dilutions of wild-type and mutant strains were plated on 7H10 agar and irradiated under 254 nm UV light. The plates were incubated at 37 °C in the dark. The images were acquired in digitization mode using the Quant LAS-4000 chemidocumentation system (GE Healthcare Life Sciences, Pittsburgh). In parallel experiments, serial dilutions of cell cultures, treated with the indicated concentrations of MMS, H2O2, or ciprofloxacin, were spread on 7H10 agar plates containing 100 µg/ml hygromycin. The survival was determined by counting viable cells.
RNA isolation and quantitative real-time PCR
The expression of recA and recX in M. smegmatis mc2155 cells, grown under aerobic or hypoxic conditions, were determined by quantitative real-time PCR using specific primers (Table 4). The cultures were harvested at the time points corresponding to early-log, exponential and stationary phases. The cell pellets were suspended in 5 ml of freshly prepared protoplast buffer (15 mM Tris-HCl, pH 8, 0.45 M sucrose, 8 mM EDTA and 4 mg/ml lysozyme) and incubated at 37 °C for 1 h. The suspension was centrifuged at 4000 rpm for 10 min at 4 °C, and the resulting pellet was resuspended in 1050 µl of RLT buffer (Qiagen India, New Delhi). The total RNA was isolated from the whole cell lysates using the Qiagen RNeasy-kit as per the manufacturer’s instructions. The RNA preparations (1.4 µg in 20 µl) were incubated with DNase I (1 U/µg) at 37 °C for 1 h. The RNA samples (0.7 µg) were denatured at 65 °C for 10 min and were used in cDNA synthesis utilizing the iScript cDNA synthesis kit (Bio-Rad Laboratories, Hercules, CA) according to the manufacturer’s instructions. The RNA samples without reverse transcriptase were included as a negative control.
The cDNA synthesis was performed using the following parameters: 25 °C for 10 min, 42 °C for 30 min followed by termination at 85 °C for 5 min. The RT-qPCRs (in 20 µl) were carried out with 2 ng of cDNA template, 10 µl of SYBR green (2X), 0.5 µl of both forward and reverse primers (0.25 µM each) in the BioRad iQ5 multicolor real time PCR detection system. The cycling program comprised initial denaturation at 95 °C for 10 min, denaturation at 95 °C for 15 sec, primer annealing at 60 °C for 30 sec and extension at 72 °C for 30 sec. Following amplification, a melting curve analysis was performed to verify the authenticity of the amplified product. Similarly, the levels of MSMEG_2725, MSMEG_2726 and MSMEG_2720 ORFs in M. smegmatis mc2155 wild-type, ΔrecA ΔrecX and ΔrecX mutant cells were determined by RT-qPCR.
Western blot analysis
The whole cell lysates of M. smegmatis mc2155 cells, grown under aerobic or hypoxic conditions, were prepared as described above (see under RNA isolation and RT-qPCR). The antibody against GroEL was purchased from Sigma-Aldrich (St. Louis, MO). The polyclonal antibodies against M. tuberculosis RecA and RecX were raised in rabbits and characterized as described14. The whole cell lysate (30 µg of protein) was boiled in SDS/PAGE buffer for 10 min, and the proteins were separated by SDS-PAGE using 10% (wt/vol) polyacrylamide gels as described36. After gel electrophoresis, the proteins were transferred onto a polyvinylidene difluoride membrane. The membranes were incubated with either anti-RecA, anti-RecX or anti-GroEL antibodies at a dilution of 1:15000, 1:1000 and 1:80000 respectively as described37. The membranes were blocked with 3% BSA in phosphate buffered saline (137 mM NaCl, 2.7 mM KCl, 10 mM Na2HPO4 and 1.8 mM KH2PO4) and washed with TBST (50 mM Tris-HCl, pH 8, 150 mM NaCl and 0.1% Tween 20). Subsequently, the membranes were incubated with peroxidase-conjugated (Sigma-Aldrich, St. Louis, MO) secondary antibody. The blots were developed using luminol and hydrogen peroxide. The digital images of Western blot bands were acquired using the Quant LAS-4000 chemidocumentation system (GE Healthcare Life Sciences, Pittsburgh, PA), and quantified using the ImageJ software.
Statistics and data presentation
Statistical significance was determined using the unpaired t-test. P-value (p) less than 0.05 indicate significant difference and p > 0.05 is not significant (ns). The symbols *, ** and *** correspond to p < 0.05, p < 0.01 and p < 0.001 respectively.
Results and Discussion
Hypoxia causes an increase in the expression of M. smegmatis recA and recX genes
During the course of infection and proliferation, M. tuberculosis is exposed to physiological stress conditions such as hypoxia and acidic pH stress, which could compromise its survival38,39,40. For instance, acute hypoxic stress arrests DNA replication and triggers robust DNA damage41,42,43. An increase in the expression of genes of the SOS pathway, including umuDC, polB, recN, sulA, uvrA, uvrB, and uvrD, begin upon DNA damage44,45,46. To this end, hypoxia-induced gene expression profiling in M. smegmatis and M. tuberculosis during latent infection has provided valuable insights on the nature of latent tubercle bacilli and its treatment47.
Previous studies in M. tuberculosis48, Thiobacillus ferrooxidans49 and Streptomyces lividans50 have demonstrated that recA is co-transcribed with recX. Furthermore, an overexpression of RecA (a positive regulator of SOS response) was found to be toxic in the absence of RecX in certain bacterial species including Pseudomonas aeruginosa51, S. lividans50, M. smegmatis52, and Xanthomonas oryzae53. These findings are consistent with the notion that RecX acts as an anti-recombinase to quell inappropriate recombination events promoted by RecA14. In contrast, an overexpression of RecA in the E. coli ΔrecX strain is not deleterious and the deletion of recX does not affect recA expression54. The recX transcription in E. coli is downregulated compared to recA under normal growth conditions because of the existence of a transcription termination site between the recA and recX coding sequences. However, a recA-recX mRNA transcript resulting from transcriptional read-through accumulates in the range of 5–10% of the total recA mRNA content54. The recX transcript was hardly detectable during the vegetative growth of E. coli, but robust expression of recX occurs following treatment with DNA damaging agents15,55.
The genomes of both M. smegmatis and M. tuberculosis contain a single copy each of recA and recX in a single operon. To investigate the expression and regulation of these genes under aerobic and hypoxic growth in M. smegmatis, a commonly used surrogate model for M. tuberculosis, the relative abundance of mRNA at various growth phases was measured by a RT-qPCR assay and normalized to that of the constitutively expressed 16S rRNA gene. The cycle threshold (Ct) values for M. smegmatis recA and recX mRNA were normalized against the Ct value of the16S rRNA gene. In contrast to E. coli15,55, significant amount of recA mRNA transcripts were seen at early-log phase under both aerobic and hypoxic culture conditions (Fig. 1A). Interestingly, hypoxic conditions enhanced the accumulation of recA mRNA by 1.5-fold at mid-log phase, and decreased thereafter as the cells entered the stationary phase. A similar pattern was observed with recX mRNA abundance under both aerobic and hypoxic conditions, albeit at reduced levels (Fig. 1B). These observations support the idea that the two genes are co-transcribed and coordinately regulated under aerobic and hypoxic growth conditions. Intriguingly, no difference was seen in the amounts of mRNA under aerobic and hypoxic growth conditions at the early-log phase. The transcriptional profiles of M. smegmatis growth-phase-specific marker genes (sigH2 and sigH7)56 was used to ascertain the times of the early-log, the mid-log and the stationary phases (Fig. 1C). In multi-drug resistant clinical strains of M. tuberculosis, the levels of both recA and recX mRNA were found to be higher than in the drug-susceptible strains and the levels of recX mRNA increased concomitantly with a rise in recA mRNA57.
(A,B) Relative levels of expression of M. smegmatis mc2155 recA and recX genes at the early log, mid-log and stationary phases under aerobic and hypoxic growth conditions. (C) Relative levels of expression of sigH2 and sigH7 genes at the early log, mid-log and stationary phases. The signal intensities were determined as described in the Methods section. The histograms represent the mean values of three independent experiments. The expression levels were determined and normalised to 16S ribosomal RNA expression and induction ratios calculated relative to the amount of transcript in the aerobic early log phase culture. The error bars represent the standard error of the mean calculated from 3 independent replicates.
However, it should be noted that the mRNA levels cannot be used as surrogates for the corresponding protein levels. Therefore, the abundance of RecA and RecX proteins in M. smegmatis was measured under aerobic and hypoxic conditions by a Western blot assay using anti-RecA and anti-RecX antibodies. GroEL was probed as a protein-loading control. The densitometric analysis of immunoblots revealed that cells accumulated higher levels of RecA under hypoxic growth conditions compared to aerobic conditions (Fig. 2A,B). A comparative analysis showed that the cells consistently accumulated 2-fold higher levels of RecA at mid-log phases relative to the early-log phase under aerobic growth conditions, which decreased at the stationary phase to levels seen at the early-log phase (Fig. 2A,B). A similar pattern was observed for RecX, albeit the levels were less pronounced than that of RecA (Fig. 2A,C). Although the mRNA and protein expression patterns were comparable, important differences were noted. First, the RecX protein was hardly detectable at early-log phase during hypoxic conditions. Second, the abundance of RecA mRNA and protein were higher compared to RecX.
(A) Expression levels of M. smegmatis mc2155 RecA and RecX proteins under aerobic and hypoxic growth conditions. (B) The quantification of relative changes in RecA protein levels under aerobic and hypoxic growth conditions. (C) The quantification of relative changes in RecX levels under aerobic and hypoxic growth conditions. The histograms represent the mean values determined by quantification of Western blots from three independent experiments. The loading control GroEL was used for normalization of RecA and RecX expression levels. The error bars represent the standard error of the mean calculated from 3 independent replicates. Significant differences are indicated by **p < 0.01, and *p < 0.05. ns, not significant.
Although, these results suggest that M. smegmatis recA and recX genes are induced under hypoxic conditions, there is no correlation between the amount of recX mRNA and corresponding protein in the early-log phase. Both M. tuberculosis and M. smegmatis have been shown to stabilize their mRNA transcripts under growth-inhibiting conditions58,59,60. Among possible mechanisms, tRNA reprogramming and selective codon-biased translation have been shown to play a role in mycobacteria in response to hypoxia61. One possible explanation for the lack of correlation between the recX mRNA versus protein level in the early log phase could be due translational repression of recX mRNA.
Construction of ΔrecX and ΔrecA ΔrecX mutant strains
The difference in the RecA and RecX protein levels in M. smegmatis indicate possible regulation of gene expression at the level of transcription. In many bacteria studied so far, the recX gene is located on the same coding strand downstream of recA and the two genes are co-transcribed48,50,53,54,62,63. However, in the lexA-recA-recX locus of Xanthomonas pathovars, each gene is expressed from its own promoter64. Furthermore, in D. radiodurans65,66, B. subtilis67 and N. gonorrhoeae26, the recA and recX genes are separated by several hundred kb in length and transcribed from their own promoters.
In a number of mycobacterial species, as well as in a few other bacteria, the 5′ region of the recX coding sequence overlaps the 3′ region of the recA gene. The overlap is 32 bp long in M. smegmatis48, while in M. tuberculosis68 and M. leprae69 the overlap is 35 bp. The effect of recX deletion on the phenotypic characteristics has been studied in various organisms7,10. The knockout mutants of recX show a range of phenotypes associated with RecA functions: the inactivation of B. subtilis recX rendered the cells sensitive to MMS and H2O225, the S. lividans recX mutants displayed decreased resistance to UV damage42 and the N. gonorrhoeae recX mutant showed a small decrease in its ability to survive DNA damage that was caused by double-strand breaks26. However, the impact of deletion of both recA and recX genes on the growth characteristics and DNA damage repair has not been investigated in any organism. Moreover, a full understanding of the in vivo role of recX in mycobacteria is not fully understood.
Previous studies have demonstrated that the M. smegmatis ΔrecA strain exhibited sensitivity to UV-induced DNA damage and fails to promote HR52. We combined the recA mutation with the deletion of recX to investigate the effects of the double mutations. For this purpose, M. smegmatis mc2155 recX single and recArecX double mutant strains were generated. As a control, the effect of recA deletion in M. smegmatis was re-evaluated for direct comparison. Using the recombineering method, which is based on a protocol developed for M. tuberculosis and M. bovis BCG28, the M. smegmatis mc2155 ΔrecA and ΔrecAΔrecX mutants were generated using 3.279 kb and 3.302 kb linear ΔrecA::hyg and ΔrecAΔrecX::hyg AES constructs, respectively. Approximately 100 ng of linear AES DNA fragments were generated by restriction digestion of the respective plasmids with EcoRV (Fig. 3A). These were transformed into competent M. smegmatis mc2155:pJV53 recombineering cells70. After 4–5 days of incubation, 8–10 Hyg-resistant colonies were found for the ΔrecX and ΔrecAΔrecX mutants. The putative mutant strains were screened using PCR to determine if the recX and recArecX genes were deleted from the chromosome (data not shown). The correct mutants were grown in 7H10 Middlebrook agar medium for 5–8 generations to allow the loss of pJV53.
Isolation of M. smegmatis mc2155 ΔrecX and ΔrecA ΔrecX mutant strains. (A) physical map of the M. smegmatis recA recX, ΔrecAΔrecX and ΔrecX regions. The horizontal lines with arrowheads on both ends represent the size of the genomic DNA fragment between NdeI and SalI restriction sites corresponding to the wild-type, ΔrecA ΔrecX and ΔrecX strains. The lightning bolt symbols indicate recognition sites for the indicated restriction enzymes. The little black boxes (adjacent to the NdeI recognition site) indicate hybridization probes used in Southern blotting experiments. (B) Southern blot analysis of genomic DNA from the wild-type and ΔrecX strains. Lane 1 and 4, molecular weight markers; 2, genomic DNA from the wild-type strain; 3, genomic DNA of the ΔrecX strain. (C) Southern blot analysis of genomic DNA of the wild-type and ΔrecAΔrecX strains. Lane 1, molecular weight markers; 2, genomic DNA of the wild-type strain; 3, genomic DNA of the ΔrecAΔrecX double mutant strain.
Genotypic and phenotypic analysis of M. smegmatis ΔrecX and ΔrecAΔrecX mutants
After screening by PCR, 2 each of the ΔrecX and ΔrecAΔrecX knockout mutants of M. smegmatis mc2155 were obtained. The ΔrecX and ΔrecAΔrecX mutants were characterized by restriction enzyme mapping and Southern blot hybridization (Fig. 3). Upon hybridization with appropriate radiolabeled probes, a 4.1 kb fragment was seen in the case of wild-type M. smegmatis mc2155 cells. The predicted 3.14 kb and 2.09 kb fragments were observed in the ΔrecX and ΔrecAΔrecX mutants respectively (Fig. 3B,C). Both these bands are smaller than 4.1 kb, indicating that the recX and recArecX genes have been deleted by allelic replacement. The frequency of allelic exchange with respect to recX and recArecX was in the range of 70% and 80% respectively.
One caveat of this analysis is that the observed effects of ΔrecX and ΔrecAΔrecX mutations could result from the polar effects of hygromycin-resistance gene insertion. In general, genetic alterations around the recA-recX locus could lead to polar effects on the expression of genes downstream of recA-recX locus. Two independent experiments were carried out to investigate the potential polar effects. First, the ΔrecX and ΔrecAΔrecX mutants were complemented with the functional copies of the recA and recX genes. The transformants were evaluated for their ability to grow in a standard culture medium and protect mutant cells against UV irradiation. Ten-fold serial dilutions were spotted on 7H10 agar plates and analyzed. As shown in Fig. 4A,B, the wild-type recA partially complemented the ΔrecA and ΔrecAΔrecX mutant strains, as deduced from their ability to support growth and provide protection against UV irradiation. However, wild-type recX failed to rescue the phenotype of ΔrecAΔrecX mutant strains observed upon DNA damage induction with UV irradiation. Since, deletion of recX had no discernible effect on its growth under normal and DNA damaging conditions, ΔrecX and its corresponding complemented strain showed similar growth as that of wild-type.
Insertion of a hygromycin resistance gene into M. smegmatis mc2155 recA-recX locus exerts no polar effect. The precA and precX denote pVV16-vector bearing one functional copy of either recA or recX gene under the control of the Hsp60 constitutive promoter. EV denotes pVV16 empty vector. precA and precX indicate plasmids bearing wild-type copies of M. smegmatis recA and recX genes respectively. These have been transformed into the indicated wild-type and mutant strains. Complementation of M. smegmatis mc2155ΔrecA ΔrecX and ΔrecX mutant strains for aerobic growth (panel A) and sensitivity against UV irradiation (panel B) with plasmids bearing wild-type alleles of M. smegmatis recA or recX. (C), quantitative real-time PCR analysis of genes around the recA-recX locus of M. smegmatis mc2155 wild-type and mutant strains. The error bars represent the standard error of the mean calculated from 3 independent replicates. Significant differences are indicated by ns, not significant.
Second, we assessed the expression of two M. smegmatis mc2155 genes, gluD (MSMEG_2725) and glnH (MSMEG_2726), located downstream of the recA recX locus in the ΔrecA ΔrecX and ΔrecX mutant strains in comparison with the wild-type strain. The M. smegmatis hyd2 (MSMEG_2720) gene located upstream of the recA-recX locus was used as a positive control. The total RNA was prepared from the wild-type, ΔrecA ΔrecX and ΔrecX mutant strains. The relative abundances of the gene transcripts were determined by quantitative RT-qPCR and normalized to that of the constitutively expressed chromosomal 16S rRNA gene. The expression levels were measured from cells grown in the late exponential growth phase. In all cases, the gene expression profiles of both the upstream and downstream ORFs were similar for the wild-type and mutant strains (Fig. 4C). Taken together, these results exclude the possibility that insertion of the hygromycin-resistance gene causes polar effects.
The M. smegmatis ΔrecA and ΔrecA ΔrecX mutant strains show impaired growth and reduced cell yield relative to the wild-type strain
To characterize the M. smegmatis ΔrecX and ΔrecA ΔrecX mutant strains, the growth profiles of the wild-type and knockout strains were measured in 7H9 Middlebrook broth at 37 °C (Fig. 5). The recX deletion had no discernible effect (compared to the wild-type strain) on the growth of M. smegmatis. Under similar conditions, recA deletion markedly increased the length of the lag phase and concomitantly reduced the exponential growth phase, suggesting that recA plays a role in the growth and viability of M. smegmatis. Furthermore, these results are consistent with the known function of RecA in the rescue of stalled or collapsed replication forks71,72,73. Because the recA and recX genes form a single operon, the impact of their deletion on M. smegmatis growth was investigated. The ΔrecA ΔrecX knockout strain exhibited a growth phenotype that was intermediate between the ΔrecA mutant and the wild-type strain; however the growth at late log and stationary phases was similar to that of ΔrecA and wild-type strains.
Deletion of recA, but not recX, renders M. smegmatis more susceptible to DNA damaging agents
Similar to other eubacteria, the mycobacterial RecA protein plays a crucial role in regulating the SOS response upon DNA damage74,75,76,77. To test whether the absence of recArecX and recX affect the ability of M. smegmatis to effectively repair damaged DNA, the mutants were exposed to a range of agents with varied mechanisms of DNA damage. In these experiments, stress was induced by exposing the ΔrecA, ΔrecX and ΔrecA ΔrecX mutant strains to UV-irradiation, MMS, H2O2 or ciprofloxacin during the exponential phase (OD600 of 0.6) of the bacterial growth. After 3 h incubation, the cells were washed and their viability was assayed by spotting ten-fold serial dilutions of the cultures on Middlebrook 7H10 agar plates containing hygromycin (100 µg/ml). The most appropriate concentration/dose of the DNA-damaging agents was determined after evaluating the differences in cell viability between the strains using plate assays. In the absence of DNA-damaging agents, all the strains exhibited similar levels of cell viability (Fig. 6). In contrast, in the presence of DNA-damaging agents, ΔrecA strain showed a pronounced growth defect accompanied with 100-fold decrease in plating efficiency relative to the wild-type strain. This phenotype is consistent with the available literature. In contrast, the lethal effect of UV, MMS or ciprofloxacin, but not H2O2, was partially blocked by deletion of the recX gene in the ΔrecA strain. Although the basis for lack of H2O2 effect is not clear, the concentration used was probably not high enough to affect growth. Interestingly, the ΔrecX strain exhibited a slightly more resistant phenotype against all four DNA-damaging agents than the ΔrecA ΔrecX strain, indicating a possible gain-of-function due to loss of recX gene. Given these results, it is apparent that recA plays an active role in the SOS response and that the sensitivity of DNA damaging agents is slightly suppressed in ΔrecX strain.
Effect of DNA-damaging agents on the survival of M. smegmatis mc2155 wild-type and ΔrecA, ΔrecA ΔrecX and ΔrecX strains. The plates were exposed to: (A) five J/m2 UV light; (B) 0.01% MMS; (C) 1 mM H2O2 and (D) 5 μM ciprofloxacin. Control represents the growth of strains without any DNA damaging agent. The results are representative data (n = 3) from three independent experiments.
Survival after treatment with different concentrations of DNA-damaging agents
Mycobacteria experience a number of adverse stress conditions, such as oxidative, nutritional and drug-induced stresses78,79,80,81,82. To further explore cell viability differences, experiments were carried out in which the cell viability was measured by colony forming units (CFUs). First, the viability of M. smegmatis mc2155 ΔrecA, ΔrecX and ΔrecAΔrecX mutants were tested in comparison with that of the wild-type by challenging them with increasing concentrations of MMS. The strains were grown in the presence of indicated concentrations of MMS, until the cultures reached an OD600 of 0.6. The cell viability was assayed by plating predetermined number of cells on 7H10 agar plates. The cells were judged alive if they were able to divide and form colonies. The mutants, unlike the wild-type strain, showed increased sensitivity to MMS in a concentration-dependent manner. The quantitative analysis indicated that the ΔrecA mutant exhibited relatively higher sensitivity to MMS, which increased with increasing concentrations of MMS (Fig. 7A). In the case of ΔrecX, the cells were ~2-fold less sensitive to MMS compared to the ΔrecA cells. On the other hand, the ΔrecA ΔrecX mutant showed more sensitivity to MMS in contrast to the ΔrecX mutant. The sensitivity of the ΔrecX mutant to MMS indicate that recX may have yet unidentified targets in addition to RecA. This assumption needs further investigation.
Survival of exponential-phase cultures exposed to a broad range of increasing concentrations of DNA damaging agents. The survival of M. smegmatis wild-type, ΔrecA, ΔrecA ΔrecX and ΔrecX strains was investigated by determining the number of CFUs. (A) The survival of cells treated with (A), MMS; (B) H2O2; (C) UV radiation and (D) ciprofloxacin. The error bars represent the standard error of the mean calculated from 3 independent replicates. Significant differences are indicated by *p < 0.05; **p < 0.01 and ***p < 0.001. ns, not significant.
Next, the sensitivities of the M. smegmatis mc2155 ΔrecA, ΔrecX and ΔrecA ΔrecX mutant strains relative to the wild-type strain were determined by exposing them to increasing concentrations of H2O2. The results show that the ΔrecA mutant was less sensitive to this treatment (Fig. 7B). The deletion of recX alone, or deletion of the recA-recX locus, had only a minor effect on the viability and proliferation of mutant cells in response to H2O2 treatment. Notably, the ΔrecA and ΔrecAΔrecX mutant strains exhibited a sensitive growth phenotype to UV irradiation and ciprofloxacin that is significantly much more severe than to MMS or H2O2 (Fig. 7C,D). Furthermore, ΔrecA strain displayed greater sensitivity to UV irradiation and ciprofloxacin than the ΔrecA ΔrecX double mutant strain.
The expression of recA and recX genes are induced by DNA damage
The regulatory elements upstream of the recA gene are not conserved in all mycobacterial species. For example, the M. tuberculosis recA gene is transcribed from two promoters: both are DNA damage-inducible, albeit through different mechanisms. The promoter P1 of M. tuberculosis recA (proximal to the start codon) can be induced following DNA damage independent of the LexA and RecA proteins. In contrast, the promoter P2 (located away from the recA start codon) is regulated by LexA, which is functionally analogous to the E. coli recA promoter83,84,85. Interestingly, the mechanism of DNA damage induction in M. tuberculosis is not fully conserved in M. smegmatis46,75. These findings emphasize the need to understand the expression and regulation of the M. smegmatis recA and recX genes and their roles in response to DNA-damaging agents.
As described above, hypoxia caused an increase in the expression of M. smegmatis recA and recX genes (Fig. 1). To further corroborate the notion that the expression of M. smegmatis recA and recX genes is damage-inducible, the kinetics of induction with and without DNA damage was determined using RT-qPCR. Total RNA samples were prepared from M. smegmatis cells harvested at 0, 3, 6, 9 and 12 h after exposure to UV light as well as from untreated cultures and analysed as described in the Methods section. The results revealed no significant differences between the recA and recX transcript levels in untreated cells. In contrast, a marked increase in the recA and recX mRNA transcripts was observed 3 h after exposure to UV radiation, and then decreased slightly thereafter. A comparison of the RT-qPCR data indicates important differences between the recA and recX transcript levels. Exposure to UV radiation led to a ~8-fold increase in recA mRNA over control, while recX by ~3-fold (Fig. 8A,B). Thus, although recA and recX mRNA exist in the same transcriptional unit, these results support the idea that the production and/or stability of recX mRNA transcript is subject to an additional posttranscriptional regulatory mechanism.
UV radiation induces the expression of recA and recX in M. smegmatis. (A) kinetics of accumulation of recA mRNA in control and following exposure to UV radiation; (B) kinetics of accumulation of recX mRNA in control and following exposure to UV radiation. (C) Representative Western blots showing the kinetics of accumulation of RecA and RecX proteins in control and UV-induced M. smegmatis cells. (D,E) Quantifications of Western blot data shown in panel C. The error bars represent the standard error of the mean calculated from 3 independent replicates.
These results led us to perform additional experiments to determine the kinetics of accumulation of RecA and RecX proteins in M. smegmatis cells with or without DNA damage. Western blotting assays were performed on whole cell lysates using polyclonal antibodies raised against RecA and RecX (Fig. 8C). The quantification of Western blots showed that the cells contained significant quantities of both RecA and RecX proteins in uninduced cells (Fig. 8D,E). By comparison, a 2-fold increase in the abundance of both RecA and RecX (over control) was seen in cells 3 h after exposure to UV radiation and decreased thereafter. Importantly, the induction of RecA and RecX proteins exhibited a pattern reminiscent of that seen in cells under hypoxic conditions (Fig. 2), although the mechanisms by which they damage DNA are likely to be different.
Concluding remarks
Numerous studies have demonstrated that recA and recX perform a broad range of functions related to DNA repair and recombination7,10. To our knowledge, the stimuli that activate the expression of M. smegmatis recA and recX genes have not been identified. In this study, the expression levels of these genes were assessed in cells at aerobic growth and in response to various stress conditions. In M. smegmatis, similar to many bacterial species, recA and recX belong to the same operon, and the recX gene is located immediately downstream of the recA gene, and share overlapping coding regions86. It was found that DNA-damaging agents induced the expression of both genes to different extents; however, the expression ratios follow a similar pattern. Interestingly, the levels of both RecA and RecX remain high under stress conditions compared to aerobic growth conditions.
Several studies have demonstrated alternative roles for recX in recombinational DNA repair promoted by RecA. While RecX protein physically interacts with RecA, and functions as a potent inhibitor of all known functions of the latter in many bacterial species14,46,48, it potentiates homologous recombination in N. gonorrhoeae and B. subtilis25,26. To gain insights into the role of recX in stress response in mycobacteria, knockout mutants of M. smegmatis recX and recArecX were constructed. Interestingly, the deletion of recX in M. smegmatis resulted in a slightly more resistant phenotype against all four DNA-damaging agents, indicating a possible gain-of-function due to loss of recX gene. The molecular basis of this effect is not clear, which seems worthwhile to explore in future studies. Whilst our analysis was mainly focused on the genetic interaction between recA and recX in recombinational DNA repair pathway, interestingly, recX seems to play an important role in bacterial growth. In summary, these findings are consistent with the idea that M. smegmatis recX plays an important role in DNA repair/recombination processes under adverse conditions, perhaps by regulating the detrimental effects of a subset of the yet unknown genes.
Abbreviations used are
DTT, dithiothreitol; EDTA, ethylene diamine tetraacetic acid; kb, kilobase; MMS, methylmethane sulfonate; ODN, oligonucleotide; PAGE, polyacrylamide gel electrophoresis; PVDF, polyvinylidene difluoride membrane; RT-qPCR, reverse transcription quantitative polymerase chain reaction; SDS, sodium dodecyl sulphate; ssDNA, single-stranded DNA; SSC, 0.15 M NaCl-0.015 M sodium citrate (pH 7.0) buffer.
References
Taddei, F. et al. Role of mutator alleles in adaptive evolution. Nature 387, 700–702 (1997).
Nakad, R. & Schumacher, B. DNA Damage response and immune defense: Links and mechanisms. Front. Genet. 7, 147, https://doi.org/10.3389/fgene.2016.00147 (2016).
Giglia-Mari, G., Zotter, A. & Vermeulen, W. DNA damage response. Cold Spring Harb. Perspect. Biol. 3, a000745 (2011).
Kowalczykowski, S. C. et al. Biochemistry of homologous recombination in Escherichia coli. Microbiol. Rev. 58, 401–465 (1994).
Kreuzer, K. N. DNA damage responses in prokaryotes: regulating gene expression, modulating growth patterns, and manipulating replication forks. Cold Spring Harb. Perspect. Biol. 5, a012674 (2013).
Bianco, P. R., Tracy, R. B. & Kowalczykowski, S. C. DNA strand exchange proteins: a biochemical and physical comparison. Front. Biosci. 3, D570–603 (1998).
Cox, M. M. Motoring along with the bacterial RecA protein. Nat. Rev. Mol. Cell Biol. 8, 127–138 (2007).
Bell, J. C. & Kowalczykowski, S. C. Mechanics and single-molecule interrogation of DNA recombination. Annu. Rev. Biochem. 85, 193–226 (2016).
Holthausen, J. T., Wyman, C. & Kanaar, R. Regulation of DNA strand exchange in homologous recombination. DNA Repair (Amst) 9, 1264–1272 (2010).
Korolev, S. Advances in structural studies of recombination mediator proteins. Biophys. Chem. 225, 27–37 (2017).
Lloyd, R. G., Picksley, S. M. & Prescott, C. Inducible expression of a gene specific to the RecF pathway for recombination in Escherichia coli K12. Mol. Gen. Genet. 190, 162–167 (1983).
Drees, J. C., Lusetti, S. L. & Cox, M. M. Inhibition of RecA protein by the Escherichia coli RecX protein: modulation by the RecA C terminus and filament functional state. J. Biol. Chem. 279, 52991–52997 (2004).
Lusetti, S. L. et al. The DinI protein stabilizes RecA protein filaments. J. Biol. Chem. 279, 30037–30046 (2004).
Venkatesh, R. et al. RecX protein abrogates ATP hydrolysis and strand exchange promoted by RecA: insights into negative regulation of homologous recombination. Proc. Natl. Acad. Sci. USA 99, 12091–12096 (2002).
Stohl, E. A. et al. Escherichia coli RecX inhibits RecA recombinase and coprotease activities in vitro and in vivo. J. Biol. Chem. 278, 2278–2285 (2003).
Drees, J. C. et al. Inhibition of RecA protein function by the RdgC protein from Escherichia coli. J. Biol. Chem. 281, 4708–4717 (2006).
Petrova, V. et al. An SOS inhibitor that binds to free RecA protein: the PsiB protein. Mol. Cell 36, 121–130 (2009).
Ryder, L., Sharples, G. J. & Lloyd, R. G. Recombination-dependent growth in exonuclease-depleted recBC sbcBC strains of Escherichia coli K-12. Genetics 143, 1101–1114 (1996).
Sandler, S. J. & Marians, K. J. Role of PriA in replication fork reactivation in. Escherichia coli. J. Bacteriol. 182, 9–13 (2000).
Uranga, L. A. et al. The cohesin-like RecN protein stimulates RecA-mediated recombinational repair of DNA double-strand breaks. Nat. Commun. 8, 15282 (2017).
Bakhlanova, I. V. & Baitin, D. M. Deinococcus radiodurans RecX and Escherichia coli RecX proteins are able to replace each other in vivo and in vitro. Genetika 52, 293–299 (2016).
Lusetti, S. L. et al. The RecF protein antagonizes RecX function via direct interaction. Mol. Cell 21, 41–50 (2006).
VanLoock, M. S. et al. Complexes of RecA with LexA and RecX differentiate between active and inactive RecA nucleoprotein filaments. J. Mol. Biol. 333, 345–354 (2003).
Yakimov, A. et al. Blocking the RecA activity and SOS-response in bacteria with a short alpha-helical peptide. Nucleic Acids Res. 45, 9788–9796 (2017).
Cardenas, P. P. et al. RecX facilitates homologous recombination by modulating RecA activities. PLoS Genet. 8, e1003126 (2012).
Stohl, E. A. & Seifert, H. S. The recX gene potentiates homologous recombination in Neisseria gonorrhoeae. Mol. Microbiol. 40, 1301–1310 (2001).
Le, S. et al. Mechanical force antagonizes the inhibitory effects of RecX on RecA filament formation in Mycobacterium tuberculosis. Nucleic Acids Res. 42, 11992–11999 (2014).
van Kessel, J. C. & Hatfull, G. F. Recombineering in Mycobacterium tuberculosis. Nat. Methods 4, 147–152 (2007).
Jain, P. et al. Specialized transduction designed for precise high-throughput unmarked deletions in Mycobacterium tuberculosis. MBio 5, e01245–14, https://doi.org/10.1128/mBio.01245-14 (2014).
Sambrook, J., Maniatis, T. & Fritsch, E. F. Molecular cloning: a laboratory manual, 2nd ed. Cold Spring Harbor Laboratory Press, Cold Spring Harbor, N.Y. (1989).
Belisle, J. T. & Sonnenberg, M. G. Isolation of genomic DNA from mycobacteria. Methods Mol. Biol. 101, 31–44 (1998).
Goude, R. & Parish, T. Electroporation of mycobacteria. Methods Mol. Biol. 465, 203–215 (2009).
Wayne, L. G. & Hayes, L. G. An in vitro model for sequential study of shiftdown of Mycobacterium tuberculosis through two stages of nonreplicating persistence. Infect. Immun. 64, 2062–2069 (1996).
Dick, T., Lee, B. H. & Murugasu-Oei, B. Oxygen depletion induced dormancy in Mycobacterium smegmatis. FEMS Microbiol. Lett. 163, 159–164 (1998).
Aung, H. L., Berney, M. & Cooka, G. M. Hypoxia-activated cytochrome bd expression in Mycobacterium smegmatis is cyclic AMP receptor protein dependent. J. Bacteriol. 196, 3091–3097 (2014).
Laemmli, U. K. Cleavage of structural proteins during the assembly of the head of bacteriophage T4. Nature 227, 680–685 (1970).
Thakur, M., Kumar, M. B. & Muniyappa, K. Mycobacterium tuberculosis UvrB is a robust DNA-stimulated ATPase that also possesses structure-specific ATP-dependent DNA helicase activity. Biochemistry 55, 5865–5883 (2016).
Rustad, T. R., Sherrid, A. M., Minch, K. J. & Sherman, D. R. Hypoxia: A window into Mycobacterium tuberculosis latency. Cell. Microbiol. 11, 1151–1159 (2009).
Vandal, O. H. et al. A membrane protein preserves intrabacterial pH in intraphagosomal Mycobacterium tuberculosis. Nat. Medicine 14, 849–854 (2008).
Gengenbacher, M. & Kaufmann, S. H. Mycobacterium tuberculosis: success through dormancy. FEMS Microbiol. Rev. 36, 514–532 (2012).
Gorna, A. E., Bowater, R. P. & Dziadek, J. DNA repair systems and the pathogenesis of Mycobacterium tuberculosis: varying activities at different stages of infection. Clin. Sci. (Lond) 119, 187–202 (2010).
Gill, W. P. et al. A replication clock for Mycobacterium tuberculosis. Nature Medicine 15, 211–214 (2009).
Ditse, Z., Lamers, M. H. & Warner, D. F. DNA Replication in Mycobacterium tuberculosis. Microbiol. Spectr. 5, https://doi.org/10.1128/microbiolspec. (2017).
Glickman, M. S. & Double-strand, D. N. A. break repair in mycobacteria. Microbiol Spectrum 2, MGM200242013 (2014).
Crew, R., Ramirez, M. V., England, K. & Slayden, R. A. MadR1, a Mycobacterium tuberculosis cell cycle stress response protein that is a member of a widely conserved protein class of prokaryotic, eukaryotic and archeal origin. Tuberculosis (Edinb) 95, 251–258 (2015).
Singh, A. Guardians of the mycobacterial genome: A review on DNA repair systems in Mycobacterium tuberculosis. Microbiology 163, 1740–1758 (2017).
Prosser, G. et al. The bacillary and macrophage response to hypoxia in tuberculosis and the consequences for T cell antigen recognition. Microbes Infect. 19, 177–192 (2017).
Papavinasasundaram, K. G. et al. Mycobacterial recA is cotranscribed with a potential regulatory gene called recX. Mol. Microbiol. 24, 141–153 (1997).
Guiliani, N. et al. Alanyl-tRNA synthetase gene of the extreme acidophilic chemolithoautotrophic Thiobacillus ferrooxidans is highly homologous to alaS genes from all living kingdoms but cannot be transcribed from its promoter in Escherichia coli. Microbiology 143, 2179–2187 (1997).
Vierling, S., Weber, T., Wohlleben, W. & Muth, G. Transcriptional and mutational analyses of the Streptomyces lividans recX gene and its interference with RecA activity. J. Bacteriol. 182, 4005–4011 (2000).
Sano, Y. Role of the recA-related gene adjacent to the recA gene in Pseudomonas aeruginosa. J. Bacteriol. 175, 2451–2454 (1993).
Papavinasasundaram, K. G., Colston, M. J. & Davis, E. O. Construction and complementation of a recA deletion mutant of Mycobacterium smegmatis reveals that the intein in Mycobacterium tuberculosis recA does not affect RecA function. Mol. Microbiol. 30, 525–534 (1998).
Sukchawalit, R., Vattanaviboon, P., Utamapongchai, S., Vaughn, G. & Mongkolsuk, S. Characterization of Xanthomonas oryzae pv. oryzae recX, a gene that is required for high-level expression of recA. FEMS Microbiol. Lett. 205, 83–89 (2001).
Pages, V., Koffel-Schwartz, N. & Fuchs, R. P. recX, a new SOS gene that is co-transcribed with the recA gene in Escherichia coli. DNA Repair (Amst) 2, 273–284 (2003).
Courcelle, J., Khodursky, A., Peter, B., Brown, P. O. & Hanawalt, P. C. Comparative gene expression profiles following UV exposure in wild-type and SOS-deficient Escherichia coli. Genetics 158, 41–64 (2001).
Singh, A. K. & Singh., B. N. Differential expression of sigH paralogs during growth and under different stress conditions in Mycobacterium smegmatis. J. Bacteriol. 191, 2888–2893 (2009).
Bhatter, P., Chatterjee, A. & Mistry, N. Kinetics of recA and recX induction in drug susceptible and MDR clinical strains of Mycobacterium tuberculosis. J. Antimicrob. Chemother. 69, 3199–3202 (2014).
Sun, C. et al. Mycobacterium tuberculosis hypoxic response protein 1 (Hrp1) augments the pro-inflammatory response and enhances the survival of Mycobacterium smegmatis in murine macrophages. J. Med. Microbiol. 66, 1033–1044 (2017).
Rustad, T. R. et al. Global analysis of mRNA stability in Mycobacterium tuberculosis. Nucleic Acids Res. 41, 509–517 (2013).
Martini, M. C., Zhou, Y., Sun, H. & Shell, S. S. Defining the transcriptional and post-transcriptional landscapes of Mycobacterium smegmatis in aerobic growth and hypoxia. Front Microbiol. 10, 591, https://doi.org/10.3389/fmicb.2019.00591 (2019).
Chionh, Y. H. et al. tRNA-mediated codon-biased translation in mycobacterial hypoxic persistence. Nat. Commun. 7, 13302, https://doi.org/10.1038/ncomms13302 (2016).
Yang, Y. C., Hsu, C. H., Chou, C. P. & Yang, M. K. Genetic organization of the lexA, recA and recX genes in Xanthomonas campestris. FEMS Microbiol. Lett. 209, 149–154 (2002).
Galvao, C. W. et al. The recX gene product is involved in the SOS response in Herbaspirillum seropedicae. Can. J. Microbiol. 49, 145–150 (2003).
Yang, M. K., Chou, M. E. & Yang, Y. C. Molecular characterization and expression of the recX gene of Xanthomonas campestris pv. citri. Curr. Microbiol. 42, 257–263 (2001).
Sheng, D. et al. Repression of recA induction by RecX is independent of the RecA protein in Deinococcus radiodurans. J. Bacteriol. 192, 3540–3544 (2010).
Sheng, D. et al. Dual negative regulatory mechanisms of RecX on RecA functions in radiation resistance, DNA recombination and consequent genome instability in Deinococcus radiodurans. DNA Repair (Amst) 4, 671–678 (2005).
Kunst, F. et al. The complete genome sequence of the gram-positive bacterium Bacillus subtilis. Nature 390, 249–256 (1997).
Cole, S. T. et al. Deciphering the biology of Mycobacterium tuberculosis from the complete genome sequence. Nature 393, 537–544 (1998).
Cole, S. T. et al. Massive gene decay in the leprosy bacillus. Nature 409, 1007–1011 (2001).
Snapper, S. B. et al. Isolation and characterization of efficient plasmid transformation mutants of Mycobacterium smegmatis. Mol. Microbiol 4, 1911–1919 (1990).
Kuzminov, A. Collapse and repair of replication forks in Escherichia coli. Mol. Microbiol. 16, 373–384 (1995).
Lusetti, S. L. & Cox, M. M. The bacterial RecA protein and the recombinational DNA repair of stalled replication forks. Annu. Rev. Biochem. 71, 71–100 (2002).
Robu, M. E., Inman, R. B. & Cox, M. M. RecA protein promotes the regression of stalled replication forks in vitro. Proc. Natl. Acad. Sci. USA. 98, 8211–8218 (2001).
Cox, M. M. Recombinational DNA repair in bacteria and the RecA protein. Prog Nucleic Acid Res. Mol. Biol. 63, 311–366 (1999).
Mizrahi, V. & Andersen, S. J. DNA repair in Mycobacterium tuberculosis. What have we learnt from the genome sequence? Mol. Microbiol. 29, 1331–1339 (1998).
Movahedzadeh, F., Colston, M. J. & Davis, E. O. Characterization of Mycobacterium tuberculosis LexA: recognition of a Cheo (Bacillus-type SOS) box. Microbiology 143, 929–936 (1997).
Sutton, M. D., Smith, B. T., Godoy, V. G. & Walker, G. C. The SOS response: recent insights into umuDC-dependent mutagenesis and DNA damage tolerance. Annu. Rev. Genet. 34, 479–497 (2000).
Master, S. S. et al. Oxidative stress response genes in Mycobacterium tuberculosis: role of ahpC in resistance to peroxynitrite and stage-specific survival in macrophages. Microbiology 148, 3139–3144 (2002).
Nambi, S. et al. The oxidative stress network of Mycobacterium tuberculosis reveals cordination between radical detoxification systems. Cell Host & Microbe 17, 829–837 (2015).
Betts, J. C. et al. Evaluation of a nutrient starvation model of Mycobacterium tuberculosis persistence by gene and protein expression profiling. Mol. Microbiol. 43, 717–731 (2002).
Liu, Y. et al. Immune activation of the host cell induces drug tolerance in Mycobacterium tuberculosis both in vitro and in vivo. J. Exp. Med. 213, 809–825 (2016).
Walter, N. D. et al. Transcriptional adaptation of drug-tolerant Mycobacterium tuberculosis during treatment of human tuberculosis. J. Infect. Dis. 212, 990–998 (2015).
Davis, E. O. et al. DNA damage induction of recA in Mycobacterium tuberculosis independently of RecA and LexA. Mol. Microbiol. 46, 791–800 (2002).
Gopaul, K. K., Brooks, P. C., Prost, J. F. & Davis, E. O. Characterization of the two Mycobacterium tuberculosis recA promoters. J. Bacteriol. 185, 6005–6015 (2003).
Papavinasasundaram, K. G. et al. Slow induction of RecA by DNA damage in Mycobacterium tuberculosis. Microbiology 147, 3271–3279 (2001).
Forse, L. N., Houghton, J. & Davis, E. O. Enhanced expression of recX in Mycobacterium tuberculosis owing to a promoter internal to recA. Tuberculosis (Edinb) 91, 127–135 (2011).
Acknowledgements
This work was supported by a grant (BT/CoE/34/SP15232/2015) under the Center of Excellence from the Department of Biotechnology, New Delhi, to K.M, who is also the recipient of J. C. Bose National Fellowship (SR/S2/JCB-25/2005) from the Department of Science and Technology, New Delhi, and Bhatnagar Fellowship from Council of Scientific and Industrial Research, New Delhi.
Author information
Authors and Affiliations
Contributions
D.P. and K.M. conceived the study and wrote the manuscript. V.K.N. provided laboratory facilities and guided D.P. and D.A. in the construction of knockout mutants. D.P. performed all of the experimental work. K.M., D.P., D.A. and V.K.N. analyzed the data. All the authors reviewed the results and approved the final version of the manuscript.
Corresponding author
Ethics declarations
Competing Interests
The authors declare no competing interests.
Additional information
Publisher’s note: Springer Nature remains neutral with regard to jurisdictional claims in published maps and institutional affiliations.
Rights and permissions
Open Access This article is licensed under a Creative Commons Attribution 4.0 International License, which permits use, sharing, adaptation, distribution and reproduction in any medium or format, as long as you give appropriate credit to the original author(s) and the source, provide a link to the Creative Commons license, and indicate if changes were made. The images or other third party material in this article are included in the article’s Creative Commons license, unless indicated otherwise in a credit line to the material. If material is not included in the article’s Creative Commons license and your intended use is not permitted by statutory regulation or exceeds the permitted use, you will need to obtain permission directly from the copyright holder. To view a copy of this license, visit http://creativecommons.org/licenses/by/4.0/.
About this article
Cite this article
Prasad, D., Arora, D., Nandicoori, V.K. et al. Elucidating the functional role of Mycobacterium smegmatis recX in stress response. Sci Rep 9, 10912 (2019). https://doi.org/10.1038/s41598-019-47312-3
Received:
Accepted:
Published:
Version of record:
DOI: https://doi.org/10.1038/s41598-019-47312-3
This article is cited by
-
The recombination regulator RecX negatively regulates heat-stable antifungal factor (HSAF) biosynthesis in Lysobacter enzymogenes
Phytopathology Research (2023)
-
A hypoxia risk signature for the tumor immune microenvironment evaluation and prognosis prediction in acute myeloid leukemia
Scientific Reports (2021)
-
Mycobacterium tuberculosis curli pili (MTP) is associated with significant host metabolic pathways in an A549 epithelial cell infection model and contributes to the pathogenicity of Mycobacterium tuberculosis
Metabolomics (2020)